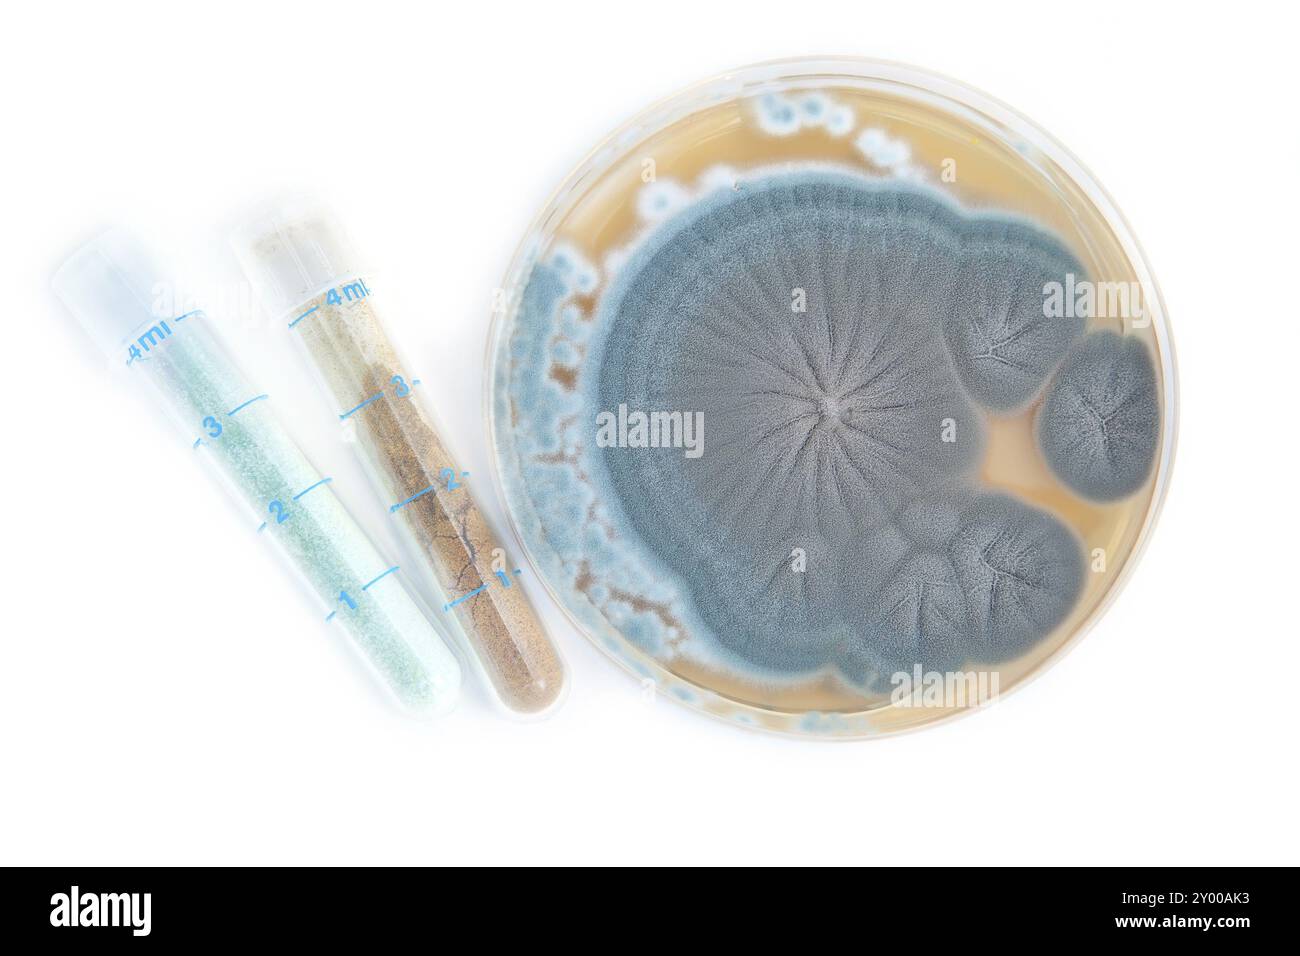
Penicillium-Pilzen auf Nährbodenplatte und Röhren mit Antibiotika auf weiß Stockfoto

Biologische studie Freisteller Stock Bilder

RF3BD853R–Der zirkadiane Rhythmus. Biologische Uhr. Schlaf-Weckzyklus. Jetlag. Vektorabbildung. Medizinisches Poster. Schematische Darstellung

RF2Y63YAP–Anatomie der tierischen Zellen, biologische tierische Zellen mit Organellen-Querschnitt, Struktur der tierischen Zellen. Lehrmaterial, Anatomie der tierischen Zelle

RMDJ5E4H–Common Shore Crab Carcinus Maenas mit entfernt Carapax aussetzen der inneren Anatomie einschließlich Kiemen

RMKYAAGG–Ein wissenschaftliches Diagramm, das die anatomische Struktur einer primitiven Weichtiere veranschaulicht und innere und äußere Merkmale für biologische Untersuchungen zeigt.

RFWB3E08–Abbildung einer konischen Labor Kolben mit Korallen und Meer Wasser. Biologische Ozeanographie.

RF2GFTEPJ–Biologisches Mittel für EINE Grubenlatrine, eine Grubentoilette oder einen septischen Tank

RF3AC94JN–Rosafarbener Wurm unter fluoreszierendem Glas. Aquarellabbildung eines Insekts. Natur studieren

RF3B8TGYR–DNA- und RNA-Struktur genetische Information und Molekularbiologie Übersicht Vektor-Illustration

RF2R06NG5–Helikale DNA-Molekül-verbundene chemische Bindung. Untersuchungen über Struktur und Zusammensetzung von Zellen und Proteinen im biologischen Laboratorium. Einfacher Cartoon Outlin

RF2DG1RJG–Bestäubung der Blume durch Biene. Selbstbestäubung, Allogamy und Kreuzbestäubung durch biotische Methoden. Nützlich für Studium Botanik und Wissenschaft Bildung

RF2Y63YEK–Kastensysteme in Ameisengesellschaften, Art der Ameisen. Soziale Struktur, verschiedene Arten von Ameisen in einer Kolonie, Art von Termiten, weiße Ameisensammlung, Zeichentrickfilm

RF2GM8Y0F–3d-Darstellung von biologischen Tierzellen mit auf Weiß isoliertem Organellenquerschnitt. Tierzelle mit platzierten Textanmerkungen zu allen Organellen

RMJ4XFX0–Tricholoma mirabile var. Nigrescens ist eine Vielzahl von Pilzen, und dieser Titel bezieht sich auf seine Illustration in einem mykologischen Werk. Es wird auf seine Eigenschaften und seine Identifizierung in der Pilzforschung untersucht.

RM2HN5J91–Paul Ekmans Smile-Forschung (falsches/reales Lächeln) Illustration der psychologischen Studie - realistisches, nicht Cartoon-thematisches berühmtes psychologisches Exmeriment

RF2G7N387–Biologisches Mittel für EINE Grubenlatrine, eine Grubentoilette oder einen septischen Tank

RF2H5BC3D–DNA-Technologie. Wissenschaftler lernen biologische Genetik integrative dna-Forschungslabor Zeichen grellen Vektor-Konzept Hintergrund

RF2WKH3JP–Biotechnologie oder Biotechnologie DNA-Forschung biologische und chemische Experimente unter Verwendung der Gentechnologie im Labor. Flachvektor Moderne Illustraten

RF3CBTNXF–Silhouetten von Insekten, die Assassin Bug, verschiedene Insektenarten auf weißem Hintergrund zeigen

RF2YRY8G4–Verschiedene bunte Kolonien von Mikroorganismen, die in Petrischalen für die biologische Forschung wachsen

RF2R06P0G–Spiral-DNA-Molekül-verbundene chemische Bindung. Untersuchungen über Struktur und Zusammensetzung von Zellen und Proteinen im biologischen Laboratorium. Einfache, flache Cartoon-Figur

RF3BEA58R–Ribosomenstruktur und Anatomie. Biologische Proteinsynthese. MRNA-Translation. Vektor. Schematische Darstellung. Detailliertes Poster.

RF2Y63YET–Pflanzenzellanatomie, Illustration der Struktur der Pflanzenzellanatomie, gemeinsame Pflanzenzellteile, Pflanzenzellanatomie, Biologiebildungsschule

RF2JTYDEH–Biologische Forschung Symbole, Zeichen, Umrisssymbole, Konzept lineare Illustration Linie Sammlung

RF2WJT9XA–Magen-Symbol. Illustration der medizinischen und medizinischen Ausbildung des menschlichen Magens für die Wissenschaft Biologie Studie

RMKCT7N5–Gleba cordata ist eine Pilzart aus der Familie der Amaurodermataceae, bekannt für ihre charakteristischen Sporenbildung, die in bestimmten ökologischen Umgebungen vorkommt.

RM2NXF33G–Paul Ekmans psychologische Studie Smile Research zeigte die Universalität von Emotionen, die in Gesichtsausdrücken gezeigt werden, hier bei Menschen ohne äußeren Kontakt.

RF2HKXD8E–Einfaches Vektor-Symbol für Biologie. Illustration Symbol Design-Vorlage für Web mobile UI-Element.

RF2G7N362–Biologisches Mittel für EINE Grubenlatrine, eine Grubentoilette oder einen septischen Tank

RF2JBTJNT–Anatomische Zeichnung des Herzens in einem Abschnitt. Hintergrund für medizinische Untersuchungen, Broschüren, Broschüren, Flyer. Visuelle Hilfe für die Untersuchung der menschlichen Anatomie.

RF2CFP6ER–Menschliche Bauchanatomie auf weißem Hintergrund isoliert. Magen und seine Teile, Vektor-Illustration mit Linien markiert. Detaillierter Vektor für die Untersuchung

RF2T99X0F–Biotechnologie oder biotechnologische DNA-Forschung als Gentechnik-Umrisskonzept. Helix-Spiral-Klon-Untersuchungsprozess. Moderne Illustration des flachen Vektors

RF3CXH852–Eine 3D-Abbildung eines Gold-Nanopartikel-Reagenzes in Mikrozentrifugenröhrchen. Es wird als hochauflösende Sonde oder Etikett in biologischen und medizinischen Anwendungen verwendet

RF2W9N6G7–Turtle Cycle Clipart, Watercolor Ocean Animal Life Cycle Poster, Wild Life Homeschool Karte, Lernspiel, Kinderschule pädagogische ClipArt, Studium c

RF2T3GA33–Medizinische elektronische Geräte, trinokulares Mikroskop zur Untersuchung in einem wissenschaftlichen Labor. Isoliert auf weißem Hintergrund.

RF2R06P8H–DNA-Molekül-verbundene chemische Bindung. Strukturuntersuchungen an Zellen und Proteinen im biologischen Labor. Einfaches schwarz-weißes Silhouettenvektorsymbol

RF2JM2T0C–Bestäubung. Honigbiene ist ein Tier mit Bestäuber, Blüten und Pollen. Detailliertes Diagramm. Fortpflanzung in Pflanzen. Vektor-Poster für Studie Botanik

RF2Y63YFM–Pflanzenzellanatomie, Illustration der Struktur der Pflanzenzellanatomie, gemeinsame Pflanzenzellteile, Pflanzenzellanatomie, Biologiebildungsschule

RF2BD0GBH–Laborglaskolben und Reagenzgläser mit Flüssigkeit. Chemische und biologische Experimente. Vektorgrafiken in flacher Ausführung.

RF3BJNPDF–Illustrierende Darstellung von extravaganten Blumenkäfern, Eudicella gralli Lebensstadien von Larven zu adulten Käfern und Kokon, isoliert auf weiß

RF2G7N349–Biologisches Mittel für EINE Grubenlatrine, eine Grubentoilette oder einen septischen Tank

RF2WJE4DX–Feiner 1809er Gravur von Platypus mit Entenschnabel (Ornithorhynchus anatinus), von oben dargestellt mit Webfüßen und Schnabel, detaillierte Kreuzschraffierung auf weiß

RF2WRM76D–Weltumwelttag, Tag mit Bäumen, die darauf wachsen, Ökologie, gemeinsame Systeme, Forschung biologische und chemische. Bio-Technologie setzt flache Vektoren modern

RFPAXKHA–Wissenschaftliche Mikroskop Symbol. Vector Illustration. Für die wissenschaftliche Forschung Konzept im flachen Stil.

RF2R06P6F–Einfache chemische Bindung durch DNA-Moleküle. Strukturuntersuchungen an Zellen und Proteinen im biologischen Labor. Einfaches schwarzes Liner-Vektorsymbol isolieren

RF2DHBPTA–Zwei nahtlose Muster. Hintergrund mit Quallen, Amöben, Paramecium und anderen Tieren. Vektor-Hintergrund für Ihr Design, biologische, Wissenschaft

RF2Y63YR0–Mikroskopvergrößerung der Blattzellen, mikroskopische Struktur der Pflanzenblätter, Wasserpflanzen-Blattzellen mit Chloroplasten, Chlorophyll oder Chloroplast-Biotechnologie

RF2B8WAMG–Symbol für Glasflaschen und Reagenzgläser im Labor. Chemische und biologische Experimente. Vektorgrafiken in flacher Ausführung.

RMBYJ206–Punnett Quadrat zeigt Mendelian Verhältnis 3 zu 1 der Wildtyp Körperfarbe (dominant), Ebenholz Farbe (rezessiv) in Drosophila.

RF3BJNPC5–Illustrierende Darstellung von extravaganten Blumenkäfern, Eudicella gralli Lebensstadien von Larven zu adulten Käfern und Kokon, isoliert auf weiß

RF2S7PDBN–Konzept biologischer Entdeckungen für Landing-Page-Vorlage. Wissenschaftler in Maske macht Forschung und wissenschaftliche Tests in Labor Menschen Szene. Vektorillustration mit flachem Zeichendesign für Webbanner

RF2YC2XTY–Vektorillustration abstrakter biologischer Zellen im linearen Stil. Symbol für Naturwissenschaften, Entdeckung und Untersuchung. Die Ikone ist perfekt für